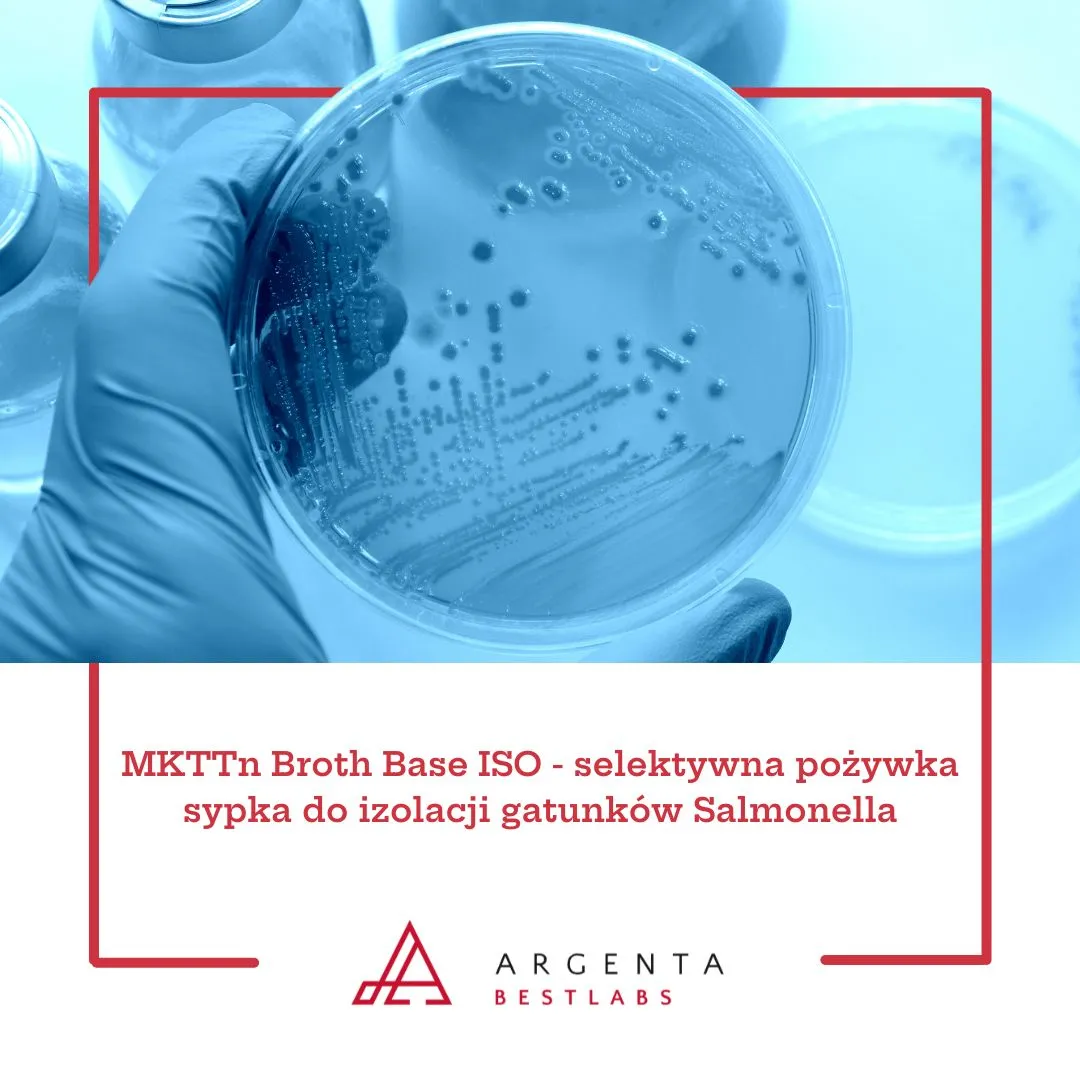
MKTTn Broth Base ISO - selektywna pożywka sypka do izolacji gatunków Salmonella

Rodzaje podłoży mikrobiologicznych Oxoid dostępnych na BestLabs
Podłoża mikrobiologiczne Oxoid wspierają codzienny workflow laboratoriów diagnostycznych, przemysłowych i kontroli jakości. Poznaj różnice między podłożami sypkimi, płynnymi, gotowymi na...
czytaj całość